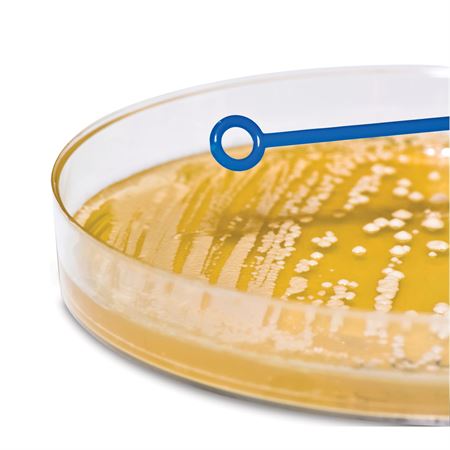
Inoculating Loop Sterile 10μL - Flexible

Inoculating Loop Sterile 10μL - Flexible
In Stock
$83.99
SKU ML21738
Discount Code: Use code TAKE5 for 5% OFF Total Purchase
Free Shipping Orders Over $100
Questions? Speak with a specialist!
 Chat with us!
Chat with us!
 Give us a call!
Give us a call!
 Email us!
Email us!
This item will take 3-5 Business Days to process and prepare for shipment
10μL - Flexible
Reduce the Risk of Contamination During Culture Transfer
- Transfer bacterial cultures while reducing the risk of contamination
- Design allows for spreading or picking colonies and cultures
- Loop ends uniformly streak gel surfaces
- Needle ends can be used for removal of colonies
- Flexible polypropylene or rigid ABS materials
- Disposable and sterile
Lessen contamination risk as you transfer cultures with these sterile, disposable loops. Loop ends uniformly streak gel surfaces, while the needle ends are ideal for removing colonies.
Reduce the Risk of Contamination During Culture Transfer
- Transfer bacterial cultures while reducing the risk of contamination
- Design allows for spreading or picking colonies and cultures
- Loop ends uniformly streak gel surfaces
- Needle ends can be used for removal of colonies
- Flexible polypropylene or rigid ABS materials
- Disposable and sterile
Lessen contamination risk as you transfer cultures with these sterile, disposable loops. Loop ends uniformly streak gel surfaces, while the needle ends are ideal for removing colonies.